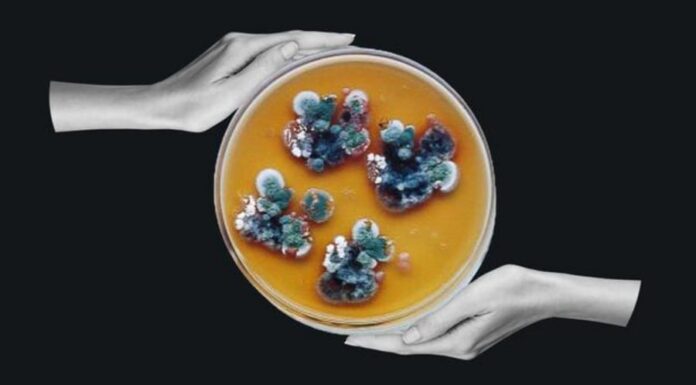
Загадочная чернобыльская плесень, которая «питается» радиацией: как ее можно использовать

Автор фото, BBC/Getty ImagesВ мае 1997 года Нелли Жданова зашла в одно из самых радиоактивных мест на Земле — заброшенные руины разрушенного ядерного реактора...
Фото предоставлено Getty ImagesКогда приходит зима, большинство людей делают одно и то же: включают обогреватель, заворачиваются в одеяло и наливают горячий чай. Но все...
Когда я пошла в поликлинику сдать анализ крови, я думала только о том, как не выглядеть слабой на камеру. Я не особо задумывался о...
Автор фото, GettyИзвержение вулкана около 1345 года могло спровоцировать цепочку событий, которые привели к смертельной пандемии в Европе – «Черной смерти», полагают ученые. Вулканическая...
Фото предоставлено Getty ImagesОдно из самых ярких астрономических явлений года, метеорный поток Геминиды, должно осветить ночное небо в течение следующих двух недель.Эти космические «гости»...
Фото: Erica Bass/Rogel Cancer Center/Michigan Medicine Ультразвук уже давно помогает врачам заглянуть внутрь тела, но сфокусированные высокочастотные звуковые волны открывают новые способы борьбы...
Фото djedzura/Getty Images На ферме есть три вида животных. Все животные — овцы, кроме трех. Все, кроме четырех, — козы. И все они...
Фото Getty Images В этом году Нобелевскую премию по литературе получил венгерский писатель Ласло Краснагоркай. Он был признан «за его впечатляющее и пророческое...
Фото Washington Post через Getty Images Они странные, лысые, подземные существа, как колбаски с зубами. И они только что раскрыли генетическую тайну долголетия....
Фото Getty Images Коллаген – что это такое, как он работает и как его принимать? Коллаген является самым распространенным белком в организме, образуя...